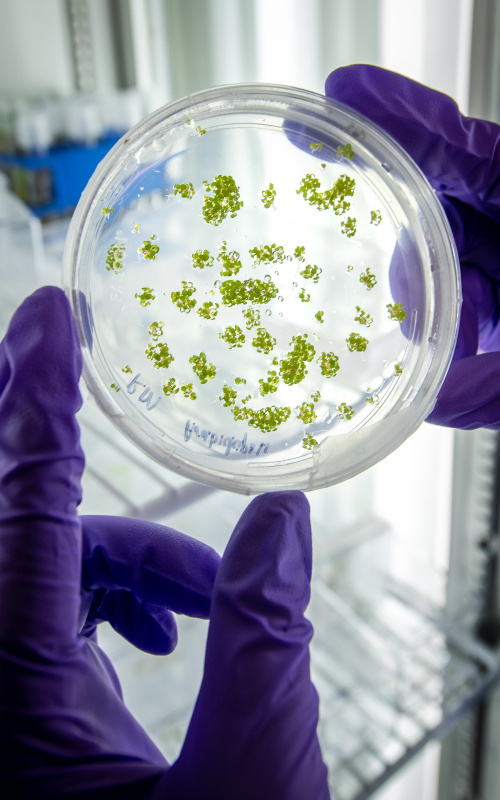
Photo of two gloved hands holding a petri dish up against a light

Office of Science Laboratories
 Ames Laboratory’s Technical & Administrative Support Facility
Ames Laboratory’s Technical & Administrative Support FacilityAmes National Laboratory, officially renamed in 2022, is a U.S. Department of Energy (DOE) national laboratory located in Ames, Iowa, and affiliated with Iowa State University. It's a key institution for research related to national security, energy, and the environment.

Argonne National Laboratory (ANL) is a federally funded research and development center located in Lemont, Illinois, and is the largest national laboratory in the Midwestern United States. It is sponsored by the U.S. Department of Energy and operated by the University of Chicago through UChicago Argonne LLC.

Brookhaven National Laboratory (BNL) is a U.S. Department of Energy (DOE) national laboratory located in Upton, New York, on Long Island. Established in 1947, it originated from a post-World War II desire to explore the peaceful applications of atomic energy.

Fermi National Accelerator Laboratory (Fermilab) is the premier particle physics laboratory in the United States, focused on understanding the mysteries of matter, energy, space, and time for the benefit of all. Located in Batavia, Illinois, approximately 40 miles west of Chicago, Fermilab is a U.S. Department of Energy (DOE) national laboratory.

Lawrence Berkeley National Laboratory (LBNL, also known as Berkeley Lab) is a federally funded research and development center located in the hills of Berkeley, California, overlooking the UC Berkeley campus. Established in 1931, it is the oldest of the national laboratories and is sponsored by the U.S. Department of Energy (DOE) and administered by the University of California system.

Oak Ridge National Laboratory (ORNL) is the largest science and energy national laboratory in the U.S. Department of Energy (DOE) system by size. It's located in Oak Ridge, Tennessee, and is managed by UT–Battelle, LLC, a partnership between the University of Tennessee and the Battelle Memorial Institute.
 Pacific Northwest National Laboratory’s Energy Sciences Center
Pacific Northwest National Laboratory’s Energy Sciences CenterPacific Northwest National Laboratory (PNNL) is a U.S. Department of Energy (DOE) national laboratory located in Richland, Washington. It's known for its courageous discovery and innovation aimed at transforming the world to live prosperously, safely, and securely. PNNL strengthens the U.S. foundation for innovation and provides solutions for the DOE, Department of Homeland Security, National Nuclear Security Administration, other government agencies, universities, and industry.

The Princeton Plasma Physics Laboratory (PPPL) is a U.S. Department of Energy (DOE) national laboratory dedicated to fusion energy science, basic sciences, and advanced technology. It is managed by Princeton University and is located in Princeton, New Jersey. PPPL is the only DOE National Laboratory with a primary mission focused on Fusion Energy Sciences.

SLAC National Accelerator Laboratory, formerly known as the Stanford Linear Accelerator Center, is a U.S. Department of Energy (DOE) national laboratory operated by Stanford University. Located in Menlo Park, California, SLAC is a leading center for research in high-energy particle physics and synchrotron-radiation physics.

Jefferson Lab's primary mission is to conduct basic research of the atom's nucleus using the lab's unique particle accelerator, known as the Continuous Electron Beam Accelerator Facility (CEBAF). The lab specializes in:
Exploring the fundamental structure of nuclear matter
Studying the quark-gluon structure of subatomic particles
Understanding the strong force that binds quarks and gluons into protons and neutrons
Investigating how quarks and gluons provide the properties of protons and neutrons
NNSA Laboratories

Lawrence Livermore National Laboratory (LLNL) is a premier research and development institution founded in 1952 and located in Livermore, California. As one of the U.S. Department of Energy's National Laboratories, LLNL has established itself as a leader in national security science and innovative research.

Los Alamos National Laboratory (LANL), established in 1943 as part of the Manhattan Project, is a premier multidisciplinary research institution focused on national security science, particularly nuclear weapons development and stewardship. Today, LANL conducts cutting-edge research across diverse fields including nuclear security, renewable energy, supercomputing, materials science, bioscience, and space exploration, with access to world-class scientific facilities and advanced technology platforms. The laboratory, located in northern New Mexico, employs thousands of scientists, engineers, and support staff who work collaboratively to address critical national security challenges while advancing fundamental science and developing innovative solutions to complex global problems.
 Sandia National Laboratories’ New Mexico Site’s Office Building
Sandia National Laboratories’ New Mexico Site’s Office BuildingSandia National Laboratories, established in 1945 as part of the Manhattan Project, is a major U.S. Department of Energy research facility with primary locations in Albuquerque, New Mexico and Livermore, California. The laboratory's core mission centers on ensuring the safety, security, and reliability of the nation's nuclear weapons stockpile, while also conducting extensive research in areas including cybersecurity, homeland security, advanced computing, and materials science. Sandia employs thousands of scientists, engineers, and support staff who develop innovative solutions to complex national security challenges through science-based engineering and cutting-edge research across multiple disciplines.
Other National Laboratories

Idaho National Laboratory (INL) is a U.S. Department of Energy (DOE) national laboratory located in southeastern Idaho. It is managed by Battelle Energy Alliance and plays a crucial role in nuclear energy research and development, as well as addressing challenges in national security, energy, and the environment.

The National Energy Technology Laboratory (NETL) is a U.S. Department of Energy (DOE) national laboratory that focuses on energy research and development, particularly for fossil energy and carbon management. Unlike many other national labs, NETL is government-owned and government-operated (GOGO), making it unique in its structure within the DOE system. It has major research sites in Albany, Oregon; Pittsburgh, Pennsylvania; and Morgantown, West Virginia.

The National Laboratory of the Rockies (NLR), formerly known as the National Renewable Energy Laboratory (NREL), is a U.S. Department of Energy (DOE) national laboratory specializing in the research and development of energy efficiency, renewable energy, energy systems integration, and sustainable transportation. Located in Golden, Colorado, it is sponsored by the Department of Energy and operated by the Alliance for Sustainable Energy, a joint venture between MRIGlobal and Battelle.

The Savannah River National Laboratory (SRNL) is an applied research and development laboratory for the U.S. Department of Energy's (DOE) Office of Environmental Management, located at the Savannah River Site (SRS) in South Carolina. SRNL is unique as it is the only DOE Environmental Management sponsored national lab.
Find a National Laboratory Near You
Highlights
-
 Read about some of the ways the National Laboratories have changed and improved the lives of millions of people for more than 75 years.
Read about some of the ways the National Laboratories have changed and improved the lives of millions of people for more than 75 years. -
 The National Laboratories are invaluable assets to the Department and our Nation.
The National Laboratories are invaluable assets to the Department and our Nation. -
The Office of Science national scientific user facilities provide researchers with the most advanced tools of modern science.November 24, 2024
The Office of Science national scientific user facilities provide researchers with the most advanced tools of modern science.November 24, 2024

